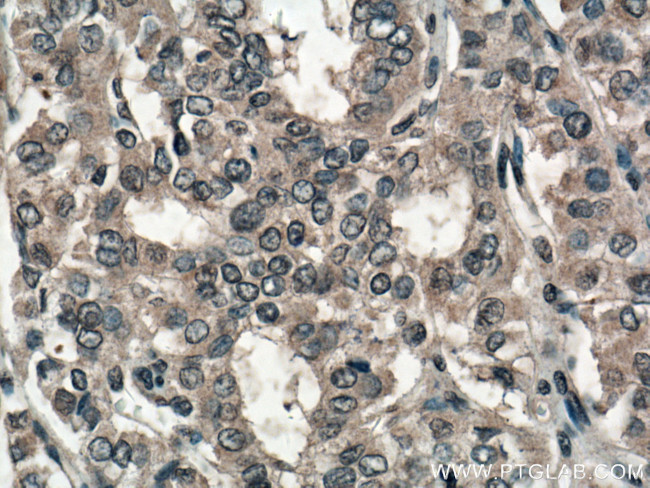
SLC24A5 Antibody in Immunohistochemistry (Paraffin) (IHC (P))

Search
Proteintech
SLC24A5 Polyclonal Antibody
{{$productOrderCtrl.translations['antibody.pdp.commerceCard.promotion.promotions']}}
{{$productOrderCtrl.translations['antibody.pdp.commerceCard.promotion.viewpromo']}}
{{$productOrderCtrl.translations['antibody.pdp.commerceCard.promotion.promocode']}}: {{promo.promoCode}} {{promo.promoTitle}} {{promo.promoDescription}}. {{$productOrderCtrl.translations['antibody.pdp.commerceCard.promotion.learnmore']}}
产品信息
27747-1-AP
种属反应
宿主/亚型
分类
类型
抗原
偶联物
形式
浓度
规格
纯化类型
保存液
内含物
保存条件
运输条件
产品详细信息
Immunogen sequence: LCLGIPWFI KTAFINGSAP AEVNSRGLTY ITISLNISII FLFLAVHFNG WKLDRKLGIV CLLSYLGLAT LSVLYELGII GNNKIRGCGG (412-500 aa encoded by BC113628)
靶标信息
The SLC24A5 gene is a member of the potassium-dependent sodium/calcium exchanger family and encodes an intracellular membrane protein with 2 large hydrophilic loops and 2 sets of multiple transmembrane-spanning segments. Sequence variation in this gene has been associated with differences in skin pigmentation.
仅用于科研。不用于诊断过程。未经明确授权不得转售。
生物信息学
蛋白别名: ion transporter JSX; K-independent Na+/Ca2+ exchanger JSX; Na(+)/K(+)/Ca(2+)-exchange protein 5; Na-Ca exchanger 5; Na/Ca-K exchanger 5; oculocutaneous albinism 6 (autosomal recessive); sodium/potassion/calcium exchanger 5; Sodium/potassium/calcium exchanger 5; solute carrier family 24 (sodium/potassium/calcium exchanger), member 5; Solute carrier family 24 member 5; solute carrier family 24, member 5; splice variant missing exon 2
基因别名: F630045L20Rik; JSX; NCKX5; NCX5; OCA6; SHEP4; SLC24A5
UniProt ID: (Human) Q71RS6, (Mouse) Q8C261
Entrez Gene ID: (Human) 283652, (Mouse) 317750, (Rat) 311387